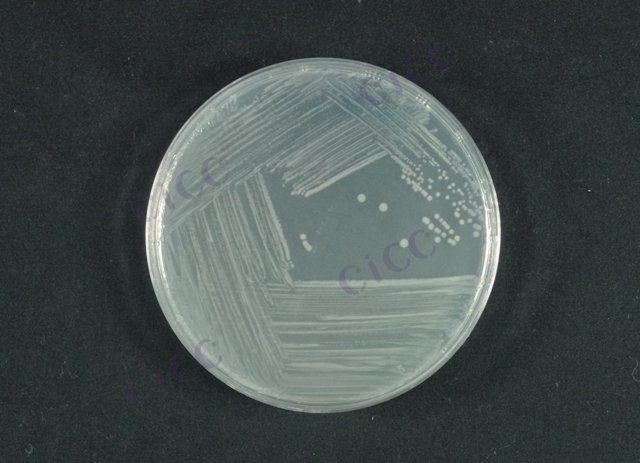
大肠埃希氏菌 Escherichia coli CICC 24176 Escherichia coli

大肠埃希氏菌 Escherichia coli CICC 24176 Escherichia coli
-
大肠埃希氏菌 Escherichia coli CICC 10047 Escherichia coli
CICC 10047 | 见证书
-
大肠埃希氏菌 Escherichia coli CICC 10221 Escherichia coli
CICC 10221 | 见证书
-
大肠埃希氏菌 Escherichia coli CICC 10222 Escherichia coli
CICC 10222 | 见证书
-
大肠埃希氏菌 Escherichia coli CICC 10223 Escherichia coli
CICC 10223 | 见证书
-
大肠埃希氏菌 Escherichia coli CICC 10224 Escherichia coli
CICC 10224 | 见证书
-
大肠埃希氏菌 Escherichia coli CICC 10242 Escherichia coli
CICC 10242 | 见证书
-
大肠埃希氏菌 Escherichia coli CICC 10243 Escherichia coli
CICC 10243 | 见证书

说明书下载: 菌种说明书 打管说明书
您正在浏览的产品:大肠埃希氏菌 Escherichia coli CICC 24176
手机版:大肠埃希氏菌 Escherichia coli CICC 24176
本公司销售的所有产品仅供实验科研使用,不用于人体及临床诊断。
本标准适用于食品中致泻大肠埃希氏菌(包括EPEC、EIEC、ETEC、EHEC、EAEC等亚型)的定性检验,覆盖食品生产、加工及流通环节的微生物安全监测[5]。
采用增菌培养结合PCR检测技术:① 样品预增菌(mTSB培养基,36℃±1℃培养18-24小时);② 选择性增菌(EC肉汤,44℃±1℃培养20小时);③ 分离培养(STEC显色培养基);④ 实时荧光定量PCR鉴定毒力基因(stx1、stx2等)[5][9]。
最低检出限为1 CFU/25g(LOD),定量限为10 CFU/g(LOQ)。PCR方法检测灵敏度达102 copies/μL[5]。
需同步进行阳性对照(ATCC 25922)和阴性对照(无菌PBS缓冲液),每批次实验需包含空白基质加标回收试验,回收率应≥70%[5][7]。
1. 样品均质(无菌均质袋,拍击式均质器,转速1200r/min);
2. 选择性增菌阶段需严格控温(44℃±0.5℃);
3. PCR扩增程序:预变性95℃ 5min,40个循环(95℃ 30s,55℃ 30s,72℃ 30s)[5][9]。
① 贝类样品需延长增菌时间至24小时;② 阳性结果需经生化验证(IMViC试验结果为++--);③ 实验环境应符合二级生物安全实验室要求[5][7]。
适用于食品中大肠埃希氏菌的定量检测(包括MPN法和平板计数法),不适用于贝类等高背景菌落样品[7]。
① MPN法:三级发酵试验(LST、EC肉汤),44.5℃产气判定;② 平板计数法(VRB-MUG培养基),荧光反应验证[7]。
每批次需做培养基性能验证(阳性菌株ATCC 25922,阴性菌株ATCC 25923),培养箱温度波动需≤0.5℃[7]。
专用于化妆品及原料中大肠埃希氏菌的定性检测,包括膏霜、液体、粉剂等剂型[9]。
检出限为1 CFU/g,采用改良CCDA培养基分离,确认试验包含β-葡萄糖醛酸苷酶活性检测[9]。
以上信息仅供参考,请以相应标准的原文为准!